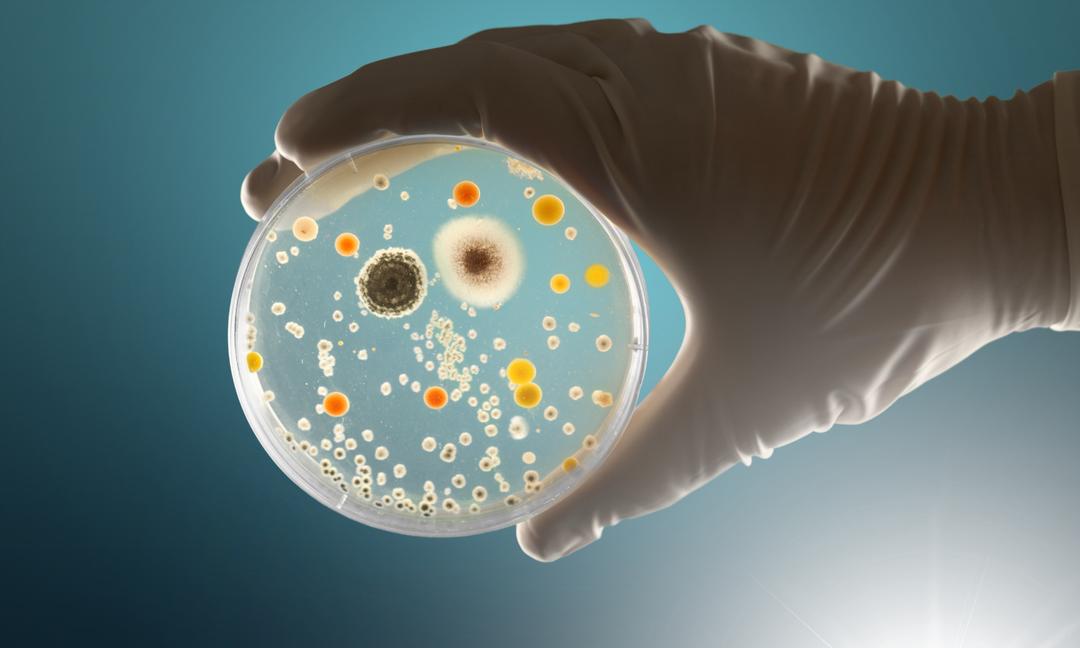

Eles são chamados Escherichia coli, Salmonela, AcinetobacterMoraxela Ou Criseobactéria, entre outros. Elas compõem dezenas de tipos de bactérias que, ao se multiplicarem, acabam formando 50 bilhões em um único centímetro cúbico de esponja. Embora a maioria não seja prejudicial aos humanos, outros podem deixá-los doentes.
Um produto propício a bactérias
Embora as esponjas sejam produtos comuns do dia-a-dia e nos quais raramente pensamos, é preciso dizer que, ao desinfectá-las, dezenas de milhares de milhões de bactérias enxame lá e faça os maiores reservatórios de bactérias ativas em toda a casa » (mais do que o vaso sanitário!). Isto foi revelado num estudo realizado em 2017 por investigadores da Universidade de Furtwangen (Alemanha) e publicado em Relatórios Científicos.
O principal motivo? O fato de estarem constantemente úmidos e repletos de resíduos de alimentos e outras substâncias contribui para o rápido desenvolvimento dessas bactérias. E só porque você molhou sua esponja com detergente ou sabão não significa que ela prosperará menos! Além disso, a Agência Nacional de Segurança Sanitária (Alças) recomenda em seu site Internet“ esponjas, panos e outros utensílios de limpeza devem ser lavados e desinfetados com frequência ».
Cerca de 50 bilhões de bactérias foram identificadas em 1 cm3 esponja de cozinha! © BillionPhotos.com, Adobe Stock
Cuidando da sua esponja entre duas trocas
Lá duração A vida útil de uma esponja dependerá principalmente da sua manutenção. Então, para mantê-lo limpo pelo maior tempo possível, você pode implementar algumas dicas como:
- enxágue abundantemente com água quente após cada uso para remover resíduos de alimentos;
- desinfete-o regularmente, colocando-o no micro-ondas durante um minuto (tenha cuidado para que esteja húmido) ou mergulhando-o durante alguns minutos numa solução diluída de lixívia, o que reduzirá significativamente a sua carga bacteriana, conforme demonstrado por investigadores da Universidade de Furtwangen;
- lave-o na máquina de lavar a 60°C, porém isso pode danificá-lo;
- seque-o bem entre os usos e evite deixá-lo de molho na pia para evitar a proliferação de bactérias.

Enxaguar uma esponja em água quente é o BABA para mantê-la! © SDF_QWE, Adobe Stock
Uma vida útil limitada
A frequência com que você deve substituir uma esponja de cozinha depende de seu uso. Limpar os restos de um prato, migalhas de pão sobre uma superfície de trabalho ou esfregar o fundo de uma panela queimada não utilizará a esponja da mesma forma. Portanto, é recomendável trocá-lo todas as semanas ou mesmo a cada duas semanas, se a manutenção for adequada.
No entanto, se a sua esponja exalar um odor desagradável, troque-a cor ou começar a desmoronar, é hora de jogá-lo fora, mesmo que já tenha passado menos de uma semana! Também é aconselhável trocar as esponjas dependendo da tarefa a ser realizada, como limpar a geladeira ou o forno.

Recomenda-se jogar uma esponja toda semana. Não muito ecológico, mas necessário para a saúde! © Vasyl, Adobe Stock
Mais fáceis de manter e alternativas mais ecológicas
Para quem deseja adotar soluções mais duráveis e higiênicas, existem alternativas como esponjas de tecido laváveis, escovas de louça, esponjas plásticas. silicone ou panos de prato suecos (uma espécie de lenços laváveis). Estas opções podem ser limpas mais facilmente e têm uma vida útil mais longa.

O tawashi são esponjas fáceis de fazer, ecológicas e cujo tecido seca mais rápido! © Roberto, Adobe Stock
Você também pode fazer tawashi. Essas esponjas japonesas criadas a partir de tecidos velhos secam mais rápido e são mais ecológicas do que esponjas de fibra sintética ou escovas de plástico para lavar louça, das quais são liberados microplásticos.
